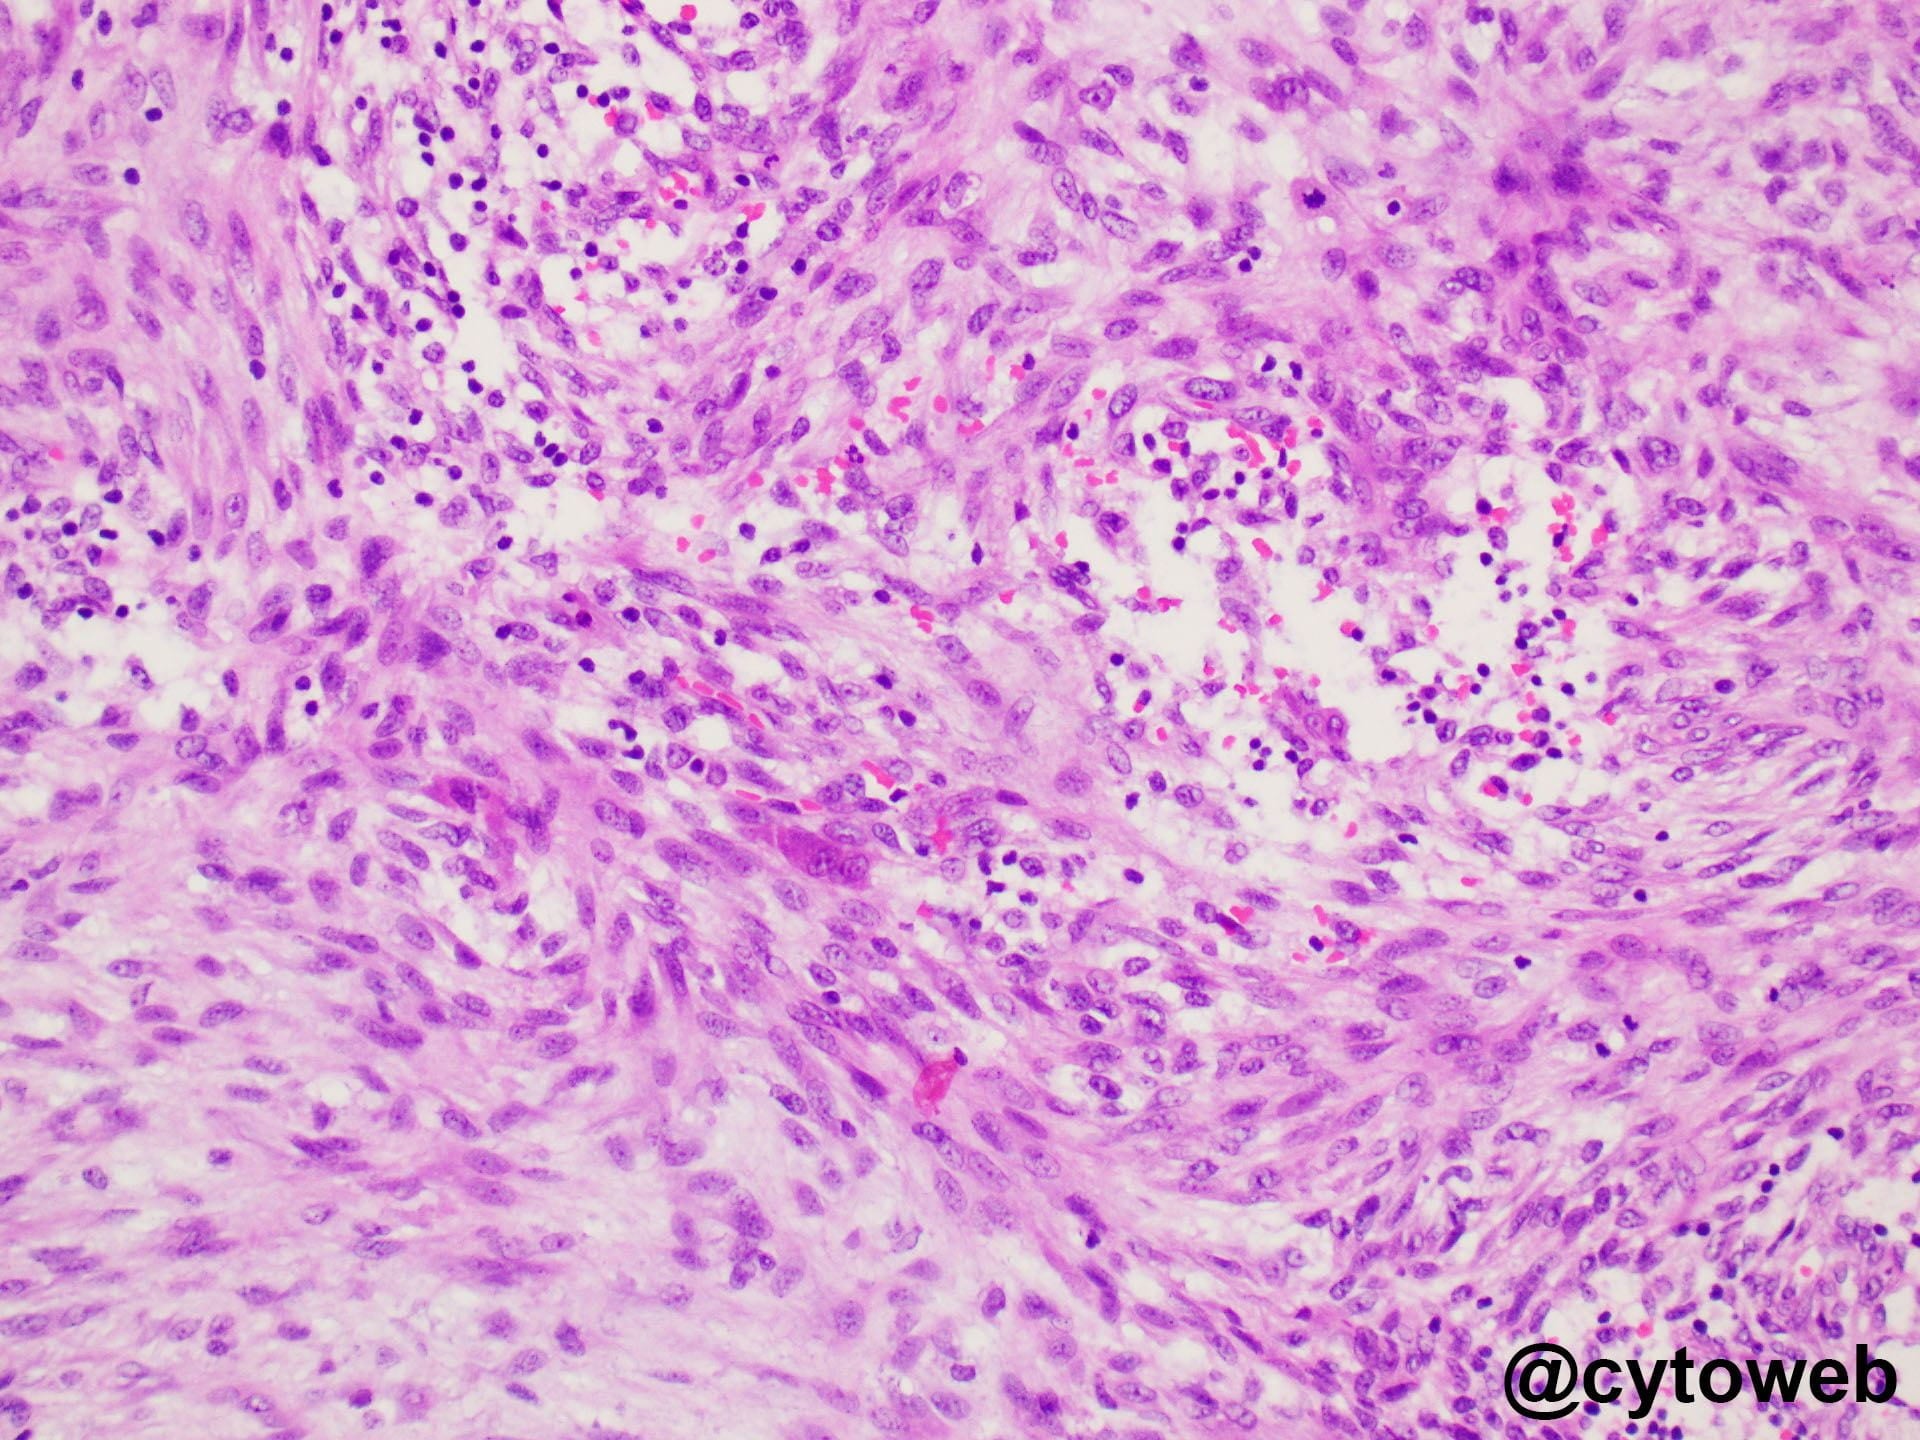

Further investigations: Ultrasound scan showed a well-defined heterogeneous hypoechoic nodule within the subcutaneous layer measuring 1.0 x 0.9 x 0.8 cm. No fatty hilum suggestive of a normal lymph node was seen. No invasion of underlying structures was present.
Differential diagnoses:
- Mesenchymal lesions/neoplasms
- Nodular fasciitis
- Spindle to stellate cells occurring in clusters and as singly dispersed cells; can be associated with mxyoid stroma
- Cells have abundant cytoplasm and tapering cytoplasmic processes
- Inflammatory cells often seen
- Can have relatively frequent mitoses
- If cell block is available – lesional cells are positive for SMA
- Schwannoma
- Clusters of slender spindle cells associated with fibrillary stroma
- Nuclei may appear wavy
- Nuclear palisading may be seen
- Generally lack single cells in the background
- Occasional larger, atypical nuclei (so-called ancient change) may be present
- If cell block is available – lesional cells are positive for S100
- Epithelial neoplasms
- Pleomorphic adenoma
- Potential differential diagnosis if suitable location (e.g. angle of jaw, submandibular region etc)
- Clusters of epithelioid to spindle epithelial cells blending into metachromatic fibrillary stroma
- Scattered singly dispersed plasmacytoid to plump cells in the background